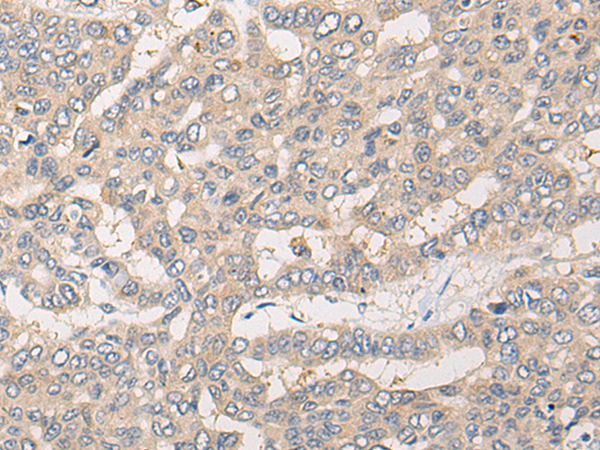

中文名稱:兔抗CLCN5多克隆抗體
|
Background: |
This gene encodes a member of the ClC family of chloride ion channels and ion transporters. The encoded protein is primarily localized to endosomal membranes and may function to facilitate albumin uptake by the renal proximal tubule. Mutations in this gene have been found in Dent disease and renal tubular disorders complicated by nephrolithiasis. Alternatively spliced transcript variants have been found for this gene. |
|
Applications: |
ELISA, IHC |
|
Name of antibody: |
CLCN5 |
|
Immunogen: |
Fusion protein of human CLCN5 |
|
Full name: |
chloride voltage-gated channel 5 |
|
Synonyms: |
XRN; CLC5; XLRH; CLCK2; ClC-5; DENTS; NPHL1; NPHL2; hCIC-K2 |
|
SwissProt: |
P51795 |
|
ELISA Recommended dilution: |
5000-10000 |
|
IHC positive control: |
Human liver cancer |
|
IHC Recommend dilution: |
25-100 |
購物車
購物車 幫助
幫助
 021-54845833/15800441009
021-54845833/15800441009
